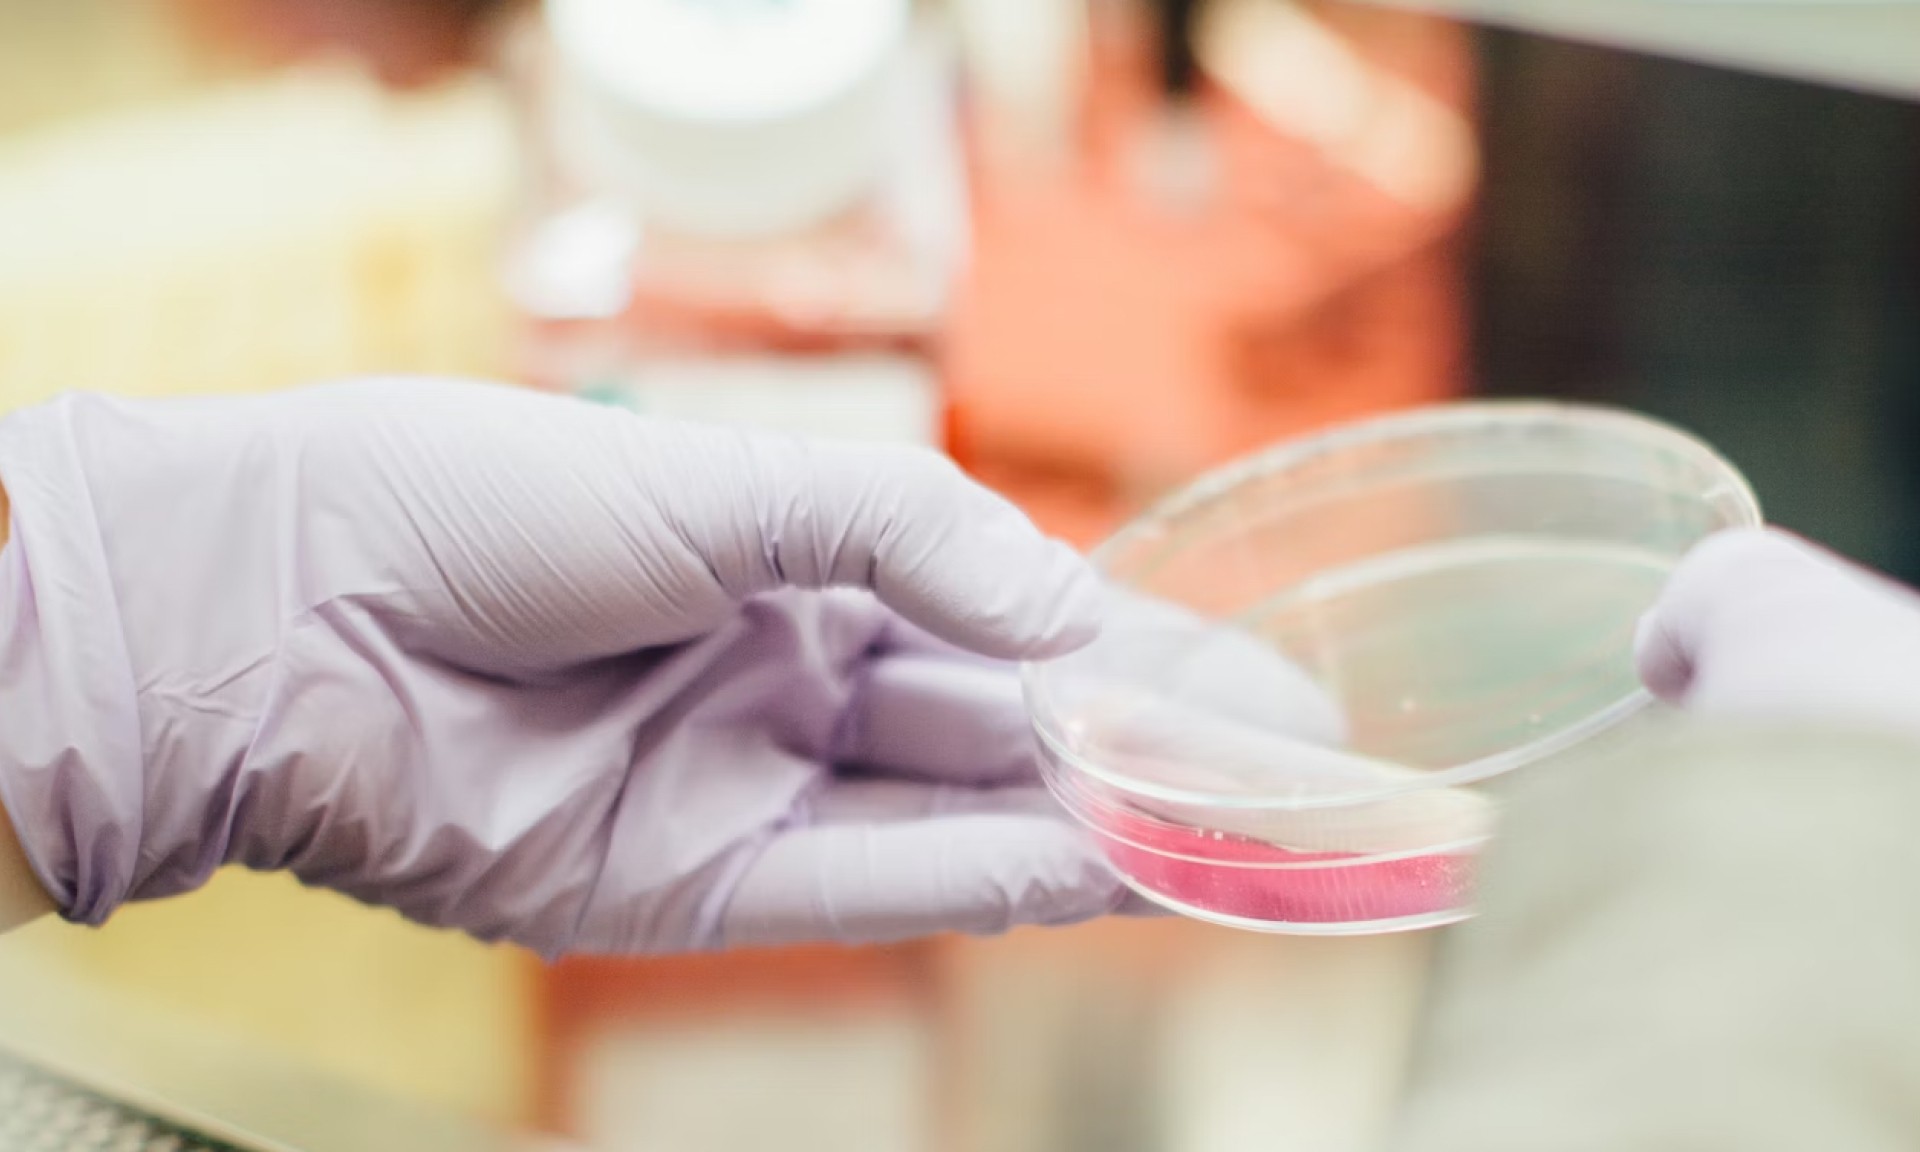
A photo of gloved hands holding a synthetic protein sample in a petri dish

EverQuest Capital Partners LLP ("we", "us", "our") is an appointed representative of Enterprise Investment Partners LLP which is authorised and regulated by the Financial Conduct Authority ("FCA") under firm reference number FRN:604439 Our firm reference number is FRN: 1018153.
This website contains financial promotions that have been approved by Enterprise Investment Partners LLP for the purposes of section 21 of the Financial Services and Markets Act 2000. The information on this website is directed only at persons in the United Kingdom who are:
- Professional clients or eligible counterparties as defined by the FCA; or
- Certified high net worth individuals, self-certified sophisticated investors, or other persons to whom financial promotions may lawfully be made under the Financial Services and Markets Act 2000 (Financial Promotion) Order 2005.
This website and any materials or information contained herein do not constitute an offer to the public or a financial promotion to retail clients unless they meet the criteria above, nor does it constitute a Direct Offer Financial Promotion. Applications for investment may only be made on the basis of the relevant documentation, copies of which are available on request. No reliance is to be placed on the information contained in this website in making such an application.
Investments of the kind referred to in this website are high-risk and are not suitable for all investors. Such investments may be illiquid, volatile, and carry a risk of total loss of capital. Past performance is not a reliable indicator of future results.
Nothing on this website should be construed as investment advice or a recommendation. If you are in any doubt about the suitability of any investment or course of action, you should consult a suitably qualified and regulated financial adviser.
This website is not intended for distribution in any jurisdiction where such distribution would be contrary to local law or regulation.